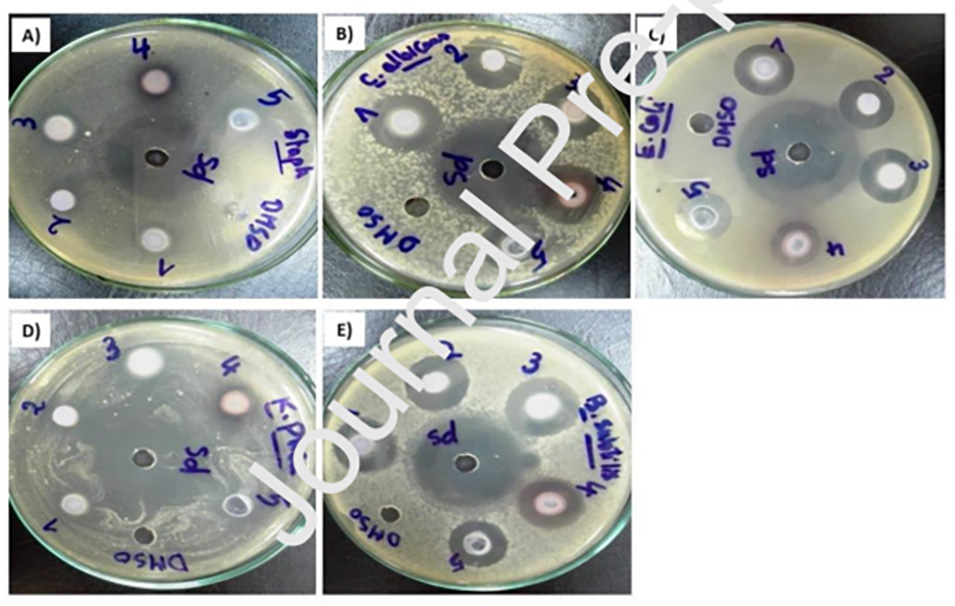

伤口长期局部应用抗生素会导致耐药菌感染。在伤口敷料中添加抗生素以确保在感染发生时释放所需的剂量仍未得到有效解决。本研究合成了一系列抗菌性α-氨基膦酸酯衍生物,并将最有效组分引入热反应性伤口敷料贴片中。通过无针电纺丝制备伤口敷料垫,并用负载有活性α-氨基膦酸酯衍生物的热响应性二十烷/纤维素纳米晶体o/w体系涂覆所得纳米纤维垫。对伤口敷料的化学、物理、热学和抗菌性能进行了表征。通过SEM分析,选择20% w/v溶液用于药物乳液负载,因为其具有较小的直径和较大的表面积。此外,电纺敷料上的药物乳液涂层改善了伤口敷料的亲水性,并且利用差示扫描量热法数据证明了垫子的热响应性。最后,发现负载药物的电纺网对测试的微生物有活性,并观察到明显的抑菌圈。总之,这种合成新型抗微生物分子家族并将其掺入源自可再生能源的纳米纤维的新方法在智能、创新型敷料中显示出巨大潜力。
图1.通过抑菌圈法测定氨基膦酸酯药物的体外抗菌活性。A)金黄色葡萄球菌,B)白色念珠菌,C)大肠杆菌,D)肺炎克雷伯菌,E)枯草芽孢杆菌。

图2.a)通过动态光散射测量乳液液滴的平均直径分布,b)CNC稳定乳液(左侧管)和未稳定的参考样品(右侧管)的照片,c)冻干后所制备的o/w二十烷乳液稳定CNC的TEM图像和b)液滴尺寸分布,包括所获得乳液的照片。

图3.不同聚合物浓度下PBS纳米纤维的SEM显微照片;氯仿溶液中的聚合物浓度为A)15%w/v,B)20%w/v,C)25%w/v,D)30%w/v。

图4.A)载药乳液颗粒、B)在25%w/v聚合物浓度下生产的未经处理的PBS纳米纤维,C)涂覆有药物-乳液的PBS纤维(红色箭头指向沉积层)的SEM显微照片,D)图像C中指示区域的高倍放大。

图5.载药纤维的接触角(CA)。A)10秒后的空白PBS纳米纤维,B)5秒后的药物-乳液负载纳米纤维,C)7秒后的药物-乳液负载纳米纤维和D)10秒后的药物-乳液负载纳米纤维。

图6.PBS纳米纤维、药物乳液和负载药物乳液的纳米纤维的FTIR图。

图7.PBS纳米纤维、二十烷O/W乳液和载药PBS纳米材料的XRD图谱。

图8.PBS纳米纤维、二十烷O/W乳液和载药PBS纳米纤维首次加热的DSC热谱图。
Copyright © 2023 专业的静电纺丝设备服务商-15年纳米纤维静电纺丝机生产设备装置厂家,北京永康乐业科技发展有限公司 苏ICP12345678 XML地图
静电纺丝机, 静电纺丝设备, 高压静电纺丝机, 静电纺丝厂家, 静电纺丝量产, 纳米纤维, 静电纺丝纳米纤维,实验室静电纺丝设备,静电纺丝装置价格,纳米纤维静电纺丝机, 静电纺丝纤维膜,静电纺丝实验装置,静电纺丝生产设备,纳米静电纺丝机